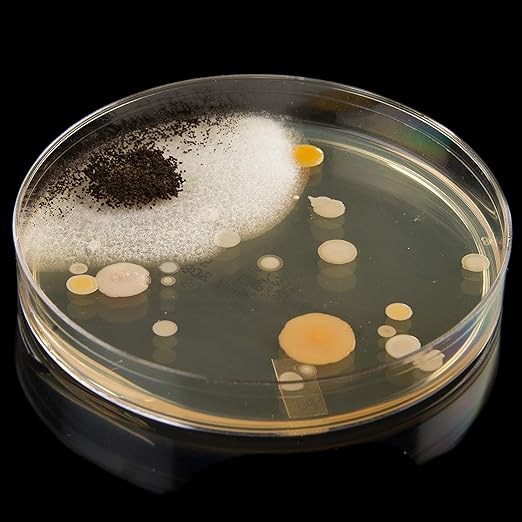

SteveSpanglerScience
Steve Spangler's Growing Bacteria Science Experiment Kit
Steve Spangler's Growing Bacteria Science Experiment Kit
Couldn't load pickup availability
About This
- POPULAR FOR SCIENCE FAIRS: Steve Spangler's Growing Bacteria Kit is our most popular kit for Science Fairs! The project is to be simple enough for young scientists to grasp, but the experiment also has the ability to be taken further!
- BECOME A MICROBIOLOGIST: Steve Spangler's Growing Bacteria Kit includes easy-to-make nutrient agar, just like microbiologists use to grow funky stuff in their lab!
- TEACH THE SCIENTIFIC METHOD: Steve Spangler's Growing Bacteria Kit includes a step-by-step scientific method guide to guide you through your experiment!
- LEARN ABOUT GERMS: This Growing Bacteria Science Experiment Kit helps students to learn about germs and where they can be found!
- ACTIVITY GUIDE INCLUDED: Everything you need for the perfect science experiment is included in the kit, all there's left to do is design your experiment, that's where our activity guide can help!
Share

리뷰
-
MINI RACE CAR
This brought back memories of my childhood obsession with mini race cars—so I bought it on a whim, and wow, this LEGO set is incredible! I completely lost track of time while building it. The details and color scheme make it feel like a real F1 machine in miniature form. And the pull-back function? So satisfying to watch it zoom! It's the kind of set that brings joy to both kids and adults. Now it proudly sits on my desk, and I can’t help but show it off!
-
THE LEGO
The LEGO Technic NEOM McLaren Formula E Race Car (42169) is a precision-engineered building set designed for ages 9 and up. Featuring 452 pieces, it replicates the sleek design of a real Formula E car with authentic details including a V10 engine and working steering. The pull-back motor adds dynamic playability, blending education with excitement. Ideal for young engineers and motorsport fans alike, this set not only fosters STEM skills but also serves as a striking display piece. A perfect gift for birthdays or special occasions, combining fun, learning, and the thrill of McLaren racing.
-
Kids Piano Keyboard
At first, I bought it just because it looked cute… but wow, it turned out to be a total hit! My little one started off banging on the keys, but now they’re actually trying to play little tunes. Every day feels like a mini concert—complete with a bow and “Mom, look at me!” The wooden design adds such a warm, classy touch to the room, so it makes me happy too.
EDUJOY
For bulk purchases of 10 or more, please contact our customer service. We will provide you with faster information.
For after-sales service (AS), please contact the customer service center of each product.
FAQ
Does it require batteries? Is it rechargeable?
It depends on the product. Some music toys use AA batteries, while newer models are USB rechargeable. Please make sure to check the specifications before purchasing.
Does it require batteries? Is it rechargeable?
It depends on the product. Some music toys use AA batteries, while newer models are USB rechargeable. Please make sure to check the specifications before purchasing.
How many songs or melodies are included, and what types of music are there?
Usually, it includes between 10 to 50 songs, featuring a variety of genres such as classical music, nursery rhymes, and nature sounds. Some toys also play different sound effects with each button.
Is it easy to clean and maintain for hygiene?
Most of the surfaces are made of plastic or silicone, making them easy to wipe clean with a wet cloth or baby wipes. However, since the toy contains electronic components, it should not be submerged in water.